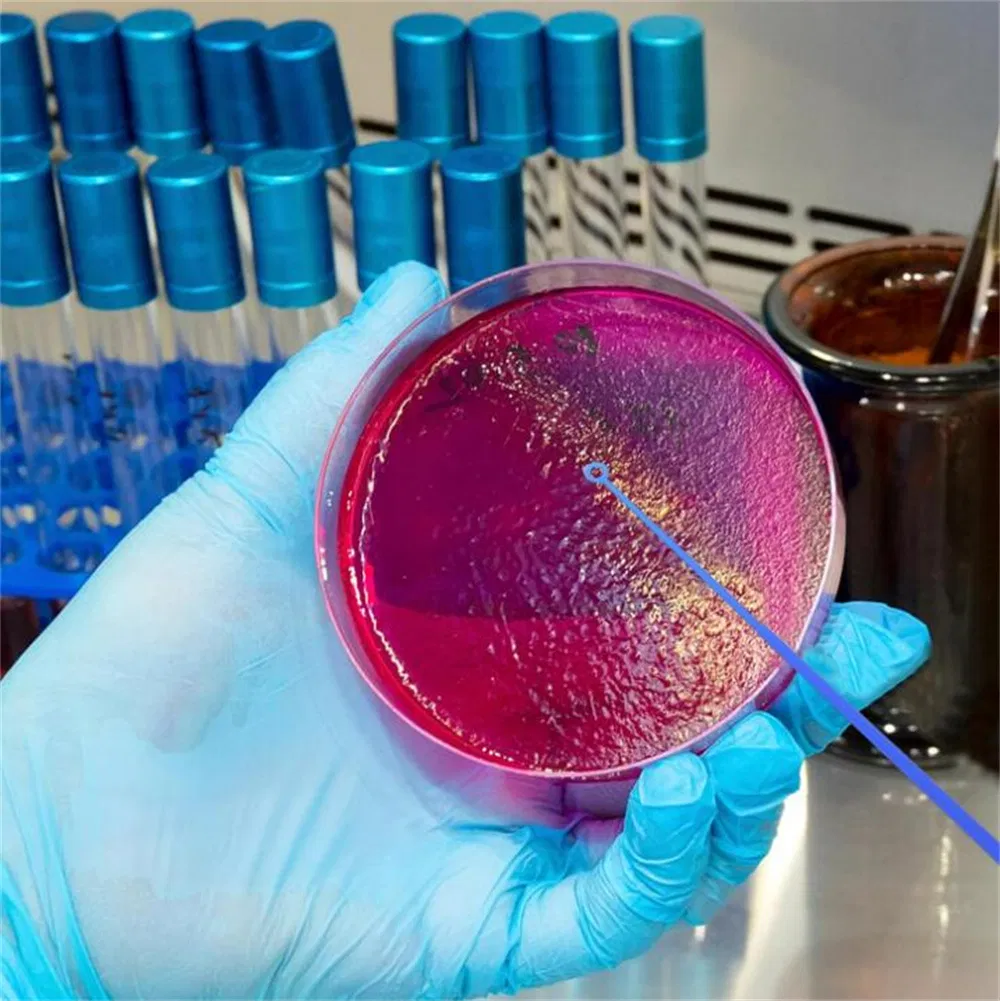
Laboratory Disposable Plastic Sterile Inoculating Loop Inoculum 1UL 10UL Inoculation Loop

1 / 5
 Breeze Medical
Breeze Medical

Available in 1μl and 10μl volumes, designed for precise bacteriological inoculation.
Strong and durable construction, not easy to break during sampling or streaking.
Safe, resealable, and repeatable sealed bag ensures aseptic integrity.
| Product Name | Type | Material | Sterile | Package |
|---|---|---|---|---|
| Lab Plastic Inoculating Loop | 1ul | PS/ABS | EO | 5000pcs/ctn |
| Lab Plastic Inoculating Loop | 10ul | PS/ABS | EO | 5000pcs/ctn |














